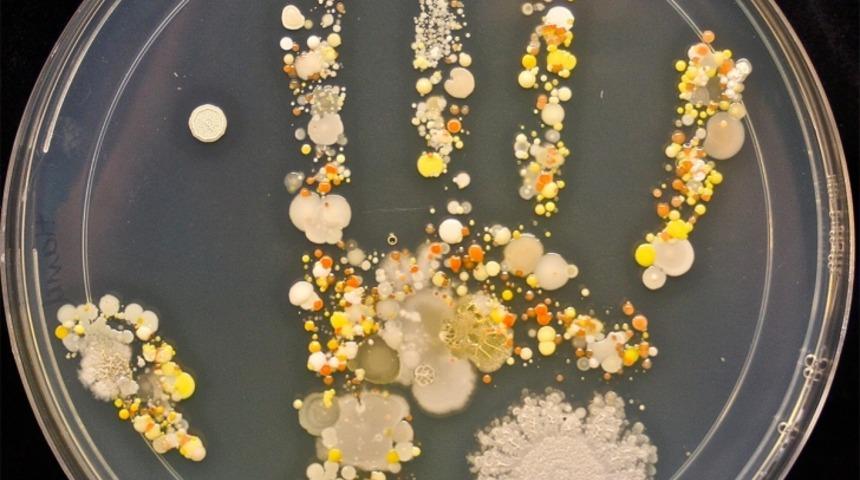
Yağlı Boya Tablolarına Fır&ccedil;a Vurmaktan Sıkıldıysanız, Sizi Mikroorganizmaların Bob Ross'ları İle Tanıştıralım

Bu anne, dışarıda arkadaşlarıyla mahalle maçı yapan çocuğunun elinden tutup banyoya götürmeden önce, petri kabına basmış. İnkübasyon süresinin sonunda ortaya çıkan sonuç, yemekten önce ellerinizi yıkayın.

Bakteriler tabii böyle göz alıcı kütahya porselen mavisi renginde değil ama bir profesör bakterilere coomassie mavisi denilen bir boya uygulamış. Bakteri kolonilerinin fazlalığına göre, boyayı absorbe ettikleri miktarlar da değiştiği için ortaya böyle bir şey çıkmış.

Bacteria Dragon ismini verdiği bu çalışmada mikrobiyoloji + resim + photoshop kabiliyetini konuşturmuş Jacob beyefendi. Bakterilere LSD mi verdi yoksa kendi mi kullandı da ortaya böyle işler çıkardı bilemiyoruz ama Tel Aviv'e yolu düşen olursa laboratuvarını Allah rızası için bi kontrol etsin.

İnsanda Secret Garden'da boyanmış izlenimi veren bu bakteri kolonilerimiz yine üstte belirttiğimiz bilim insanına ait. Biz laboratuvarda gram pozitif mi yoksa gram negatif mi diye kristal violelerle boyadığımız bakterilerin izlerini lavabodan ciflerken amcamgiller sanat yapıyor. Adalet bu mu?

Bioart çalışmalarında LSD etkisinden fazlaca nasibini almış bakteriler...


Görüldüğü gibi sol alt köşede bulunan mikrobiyal resimde Yaprak Dökümü dizisinden tanıdığımız Ali Rıza Bey'in "YETHEEER DUYMAK İSTEMİYORUM" sahnesi resmedilmiştir. Orta alttaki resimde ise Katrina Kasırgası'nın sanatçıda bıraktığı derin izler... şaka şaka!

E.coli'lerin spesifik yerleştirilmeleri, fotoğraf üstünde büyümeleri, flourescent proteini dönüşümü, radyasyon ve akrilik reçine gibi zahmetli işler sonucunda ortaya çıkan bakteriyel Einstein.

ABİ PARDON DA NEDEN BANA PLAYBOY TAVŞANI KULAĞI TAKTIN?

Sen koskoca mikrobiyolog, Australopithecus afarensis isketeli çiz ama bizi ütü ile çekilmiş görsele mahkum et, ayıp.

Resim kabiliyetim yok diye üzülme, bakteriler hislerine kelimelerle de tercüman olur. Gerçi bu yöntemi tercih eder miyiz... hayır... ya da ediyoruz... bilemiyorum...

Dediğimiz gibi, minnoş bakterilerimiz hislerinize tercüman olabilir, sizin adınıza sorular sorabilir ama asla romantik anların değişmez fon müziği olan İYAYAAAİYAVİLOLVEYZLAVYU'yu söyleyemez. Onu da bi' zahmet siz yapın.